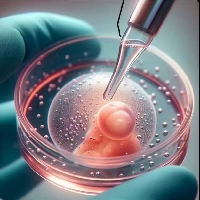

北京市相亲推荐:轻风山蹦蹦 (大学教授)
正在寻找北京市地区的大学教授作为伴侣吗?轻风山蹦蹦是一位优秀的北京市单身大学教授,今年26岁,拥有博士 中国人民大学学历。在MeetKnow,您可以发现更多像轻风山蹦蹦这样优秀的北京市单身男女。无论您是想找大学教授男朋友还是女朋友,我们都提供严格的实名认证服务,助您在北京市快速脱单。

照片登录可见
轻风山蹦蹦
北京市26岁大学教授博士 中国人民大学
实名认证
人脸认证
婚姻状况认证
工作认证
学历认证
关于我
喜欢大自然但比较宅嘿嘿 喜欢打游戏和健身,工作会比较忙,有稳定收入
基础资料
身高
160cm
收入
年薪30-50万
我的标签
择偶标准
年龄:20-32岁
身高:177-188cm
学历:本科、硕士
希望情绪稳定,有责任心,要是喜欢狗狗就更好了
相册墙
想认识 TA?
注册成为会员,解锁高清照片并获取联系方式。
安全保障
平台人工审核,拒绝杀猪盘。所有会员均需实名认证,保护您的交友安全。
关于 轻风山蹦蹦 的常见问题
Q: 轻风山蹦蹦是真实用户吗?
是的。作为一家北京市真实靠谱的相亲平台,MeetKnow 坚守严格的审核标准。我们要求轻风山蹦蹦以及每一位北京市会员都必须通过实名认证、学历认证、工作认证、婚姻状况认证、人脸认证、资产认证等多重核验,确保资料真实有效。
Q: 如何联系轻风山蹦蹦?
为了打造北京市本地安全、纯净的交友环境,请您注册并登录 MeetKnow。通过身份认证后,您即可解锁轻风山蹦蹦的完整联系方式并申请添加好友。